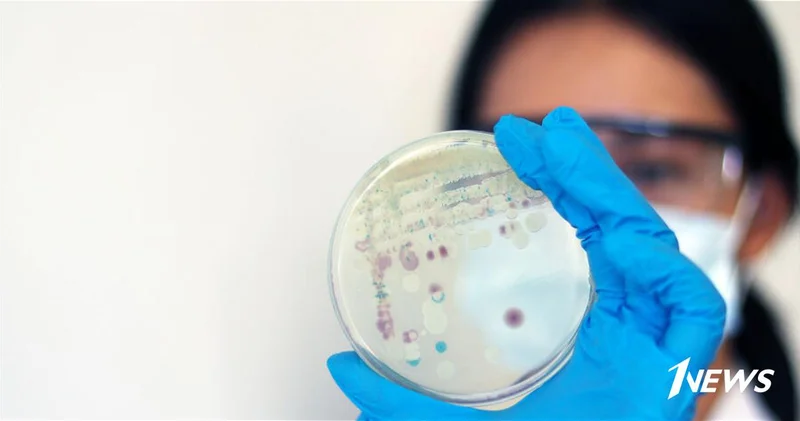

Иранский эксперт: Каспийскому морю грозит судьба Арала
По данным сайта Zerkalo.az, передает Icma.az.
Каспийское море ожидает участь Аральского моря если не будут приняты серьезные меры в связи с его обмелением.
Об этом заявил научный сотрудник Иранского института политических и международных исследований, посол Мохсен Мохаммади на 13-м заседании Форума мозговых центров Совещания по взаимодействию и мерам доверия в Азии (СВМДА).
«Изменения климата создают новые угрозы. Наблюдается снижение уровня воды в Каспийском море. Если не будут приняты серьезные меры, его судьба может повторить трагический путь Аральского моря», — сказал он.
Эксперт также отметил, что Иран всегда направлял свое основное внимание на расширение региональных торговых связей.
Другие новости на эту тему:Государственное агентство водных ресурсов озвучило цели по Каспийскому морю
16 Ноября 2024 16:42
Милли Меджлис одобрил проект по Каспийскому морю Новости Азербайджана
29 Ноября 2024 14:04
Иран остался без воды: жители уезжают к Каспийскому морю
29 Июля 2025 17:56
В Туркменистане прошло заседание Рабочей группы по Каспийскому морю
16 Сентября 2025 11:05
Лейла Алиева приняла участие в дискуссиях по Каспийскому морю на COP29
16 Ноября 2024 20:38
Просмотров:213
Эта новость заархивирована с источника 09 Сентября 2025 15:15 



Войти
Новости
Погода
Магнитные бури
Время намаза
Драгоценные металлы
Конвертор валют
Кредитный калькулятор
Курс криптовалют
Гороскоп
Вопрос - Ответ
Проверьте скорость интернета
Радио Азербайджана
Азербайджанское телевидение
О нас
TDSMedia © 2025 Все права защищены







Самые читаемые